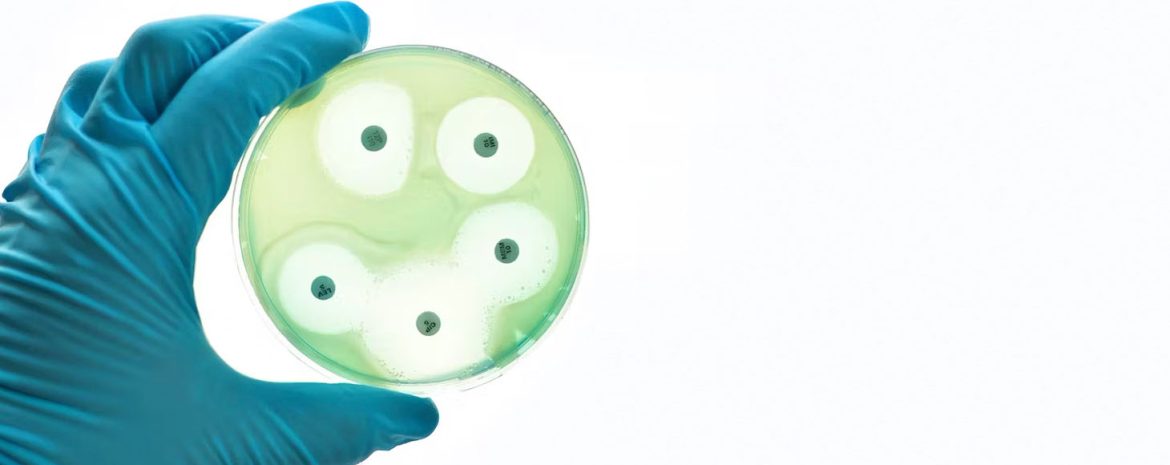
Ο ΠΟΥ ανησυχεί για την αυξημένη αντιμικροβιακή αντίσταση

Η υπερκατανάλωση αντιβιοτικών βλάπτει σημαντικά την αποτελεσματικότητά τους και αυξάνει την αντίσταση στις αντιμικροβιακές ουσίες.
«Αυτή η αντίσταση, πιθανόν να γίνει υπεύθυνη για εκατομμύρια θανάτους παγκοσμίως μέχρι το 2050», προειδοποιεί η ευρωπαϊκή υπηρεσία του Παγκόσμιου Οργανισμού Υγείας.
«Αν η AMR, η αντίσταση στις αντιμικροβιακές ουσίες (στις οποίες ανήκουν τα αντιβιοτικά), αποτελεί φυσικό φαινόμενο, η ανάπτυξη και η εξάπλωση των υπερμικροβίων (superbugs) ενισχύεται από την καταχρηστική χρήση των αντιμικροβιακών ουσιών.
Το γεγονός αυτό, καθιστά την αποτελεσματική αντιμετώπιση των λοιμώξεων δυσκολότερη», αναφέρεται σε ανακοίνωση που εκδόθηκε σήμερα από τον ΠΟΥ, που αφορά 53 χώρες και η ακτίνα ευθύνης του φθάνει μέχρι την κεντρική Ασία.
«Ολες οι χώρες της περιοχής μας έχουν θεσπίσει κανόνες με στόχο την προστασία των πολύτιμων αντιβιοτικών από την κατάχρηση (…).
Η εφαρμογή αυτών των κανόνων θα επέτρεπε την επίλυση των περισσότερων προβλημάτων που προέρχονται από την κατάχρηση των αντιβιοτικών», τονίζει ο Ρομπ Μπάτλερ, υπεύθυνος του τμήματος Μεταδοτικών Νόσων.
Ο οργανισμός του ΟΗΕ θεωρεί ότι, αν δεν υπάρξει άμεση επέμβαση, η AMR μπορεί να προκαλέσει μέχρι και 10 εκατομμύρια θανάτους μέχρι το 2050.
Βασική πηγή ανησυχίας για τις υγειονομικές αρχές, η κακή συνταγογράφηση.
Μελέτη πραγματοποιήθηκε σε 14 χώρες, που βρίσκονται στην ανατολή Ευρώπη και την κεντρική Ασία.
Τα αποτελέσματά της δείχνουν ότι οι λόγοι που καταγράφονται για να αιτιολογηθεί η λήψη αντιβιοτικών είναι:
στο 24% των περιπτώσεων το συνάχι που συνοδεύεται από συμπτώματα γρίπης (16%), ο πονόλαιμος (21%) και ο βήχας (18%).
«Η κατάσταση αυτή είναι ανησυχητική, διότι τα συμπτώματα αυτά προκαλούνται συχνά από ιούς για την αντιμετώπιση των οποίων τα αντιβιοτικά δεν έχουν καμία αποτελεσματικότητα», επισημαίνεται στην ανακοίνωση.
Ακόμη χειρότερα, σύμφωνα με την μελέτη που αφορά την Αλβανία, την Αρμενία, το Αζερμπαϊτζάν, την Λευκορωσία, την Βοσνία-Ερζεγοβίνη, την Γεωργία, το Καζακστάν, το Κιργιστάν, το Μαυροβούνιο, την Βόρεια Μακεδονία, την Μολδαβία, το Τατζικιστάν, την Τουρκία και το Ουζμπεκιστάν, το ένα τρίτο των ανθρώπων που ερωτήθηκαν καταναλώνουν αντιβιοτικά χωρίς συνταγή.
Σε ορισμένες χώρες, άνω του 40% των αντιβιοτικών αγοράζονται χωρίς ιατρική συνταγή, ποσοστό πέντε φορές μεγαλύτερο από αυτό που απαντάται στις χώρες της Ευρωπαϊκής Ένωσης σύμφωνα με μελέτη του 2022.
Σύμφωνα με τον ΠΟΥ, άλλος κίνδυνος που προέρχεται από την αντίσταση στα αντιβιοτικά είναι η αύξηση των ανισοτήτων, διότι οι άνθρωποι με χαμηλότερο μορφωτικό και βιοτικό επίπεδο είναι αυτοί που εφαρμόζουν περισσότερο αυτές τις πρακτικές, γεγονός που «δείχνει ξεκάθαρα την ανάγκη για εκπαίδευση και ευαισθητοποίηση».
Η ανάπτυξη αντίστασης στα αντιβιοτικά, μπορεί να βρίσκει την αιτιολογία της και σε κεκτημένες κοινωνικές και πολιτισμικές συνήθειες, όπως το γεγονός ότι «υπάρχουν άνθρωποι που δεν ολοκληρώνουν την θεραπεία με αντιβιοτικά για να κρατήσουν απόθεμα για την επόμενη φορά που θα αρρωστήσουν ή που μοιράζονται τα αντιβιοτικά με άρρωστο συγγενή ή γείτονα».